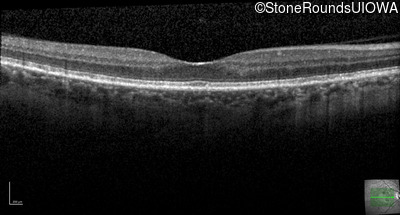
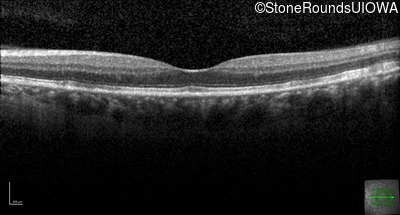

Case
SR2197
Student Mode
Late Onset Retinal Dystrophy (IIIA3)
Female
Female
Hidden
SR2197
Student Mode
Late Onset Retinal Dystrophy (IIIA3)
Female
Female
History
This 61 year old woman reports some moderate night blindness over the past 10 years.
Diagnosis & molecular findings
| Disease | Gene | Allele 1 variant(s) | Allele 2 variant(s) | Inheritance mode |
|---|---|---|---|---|
| Late Onset Retinal Dystrophy | C1QTNF5 | Ser163Arg AGC>AGA | AD |
Disease:
Gene:
Allele 1:
Ser163Arg AGC>AGA
Allele 2:
Inheritance:
AD